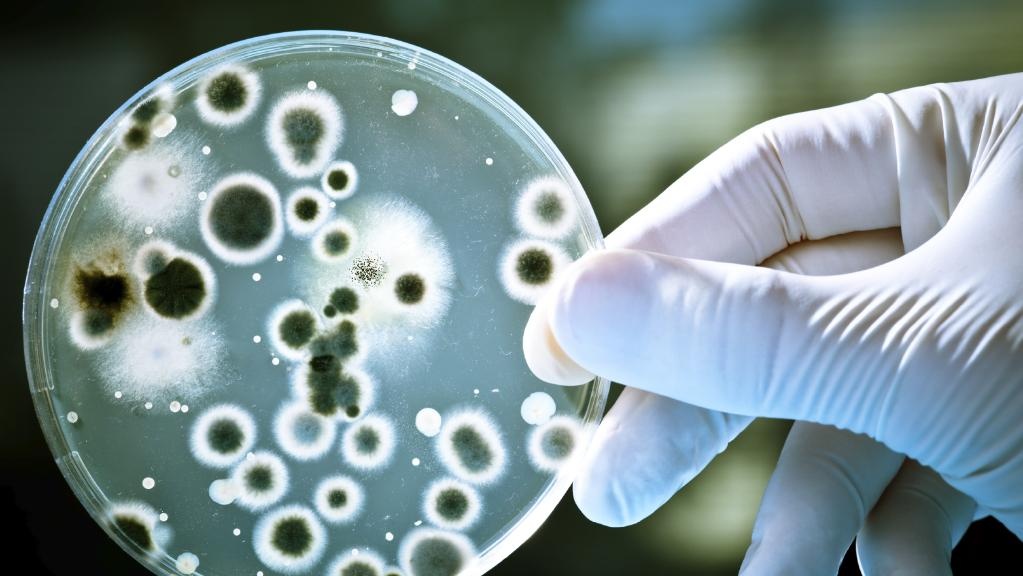

Nhiễm khuẩn bệnh viện là những nhiễm khuẩn không xuất hiện ở bệnh nhân khi nhập viện, nhưng phát triển trong quá trình lưu trú tại đây. Hai dạng chính của loại nhiễm khuẩn này là tự nhiễm và nhiễm chéo.
Trong đó, tự nhiễm là khi người bệnh có mầm nhiễm khuẩn trên người nhưng không có dấu hiệu khi nhập viện. Nhiễm khuẩn phát triển trong quá trình ở tại bệnh viện do sự thay đổi trong miễn dịch của chính bệnh nhân.
Nhiễm khuẩn chéo là khi bệnh nhân tiếp xúc với các tác nhân gây bệnh mới trong thời gian ở bệnh viện, nhiễm và sau đó phát triển nhiễm trùng.
|
| Vi khuẩn xuất hiện khắp nơi, từ trên cơ thể người tới các đồ vật. Ảnh: Courier Mail. |
Người bình thường luôn có vi khuẩn trên cơ thể. Da của con người có khoảng 100 đến 10.000 vi sinh vật trên mỗi cm2. Nhiều loài vi sinh vật sống trong màng nhầy niêm mạc của con người và tạo thành một hệ bình thường. Tuy nhiên, các mô này không bị nhiễm trùng.
Khi các vi sinh vật xuyên qua da hay màng nhầy niêm mạc, chúng đi vào các mô dưới da, cơ, xương hay khoang trong cơ thể - nơi bình thường vô trùng - và có thể phát triển thành nhiễm trùng.
Nhiễm khuẩn bệnh viện bắt nguồn từ đâu?
Tại các cơ sở y tế, nguồn nhiễm trùng có thể đến từ nhân viên bệnh viện, bệnh nhân và môi trường vô tri. Môi trường bệnh viện, nước hay thức ăn có thể chứa những nguồn bệnh và gây bùng phát bệnh như ở cộng đồng bên ngoài. Thậm chí, các dược phẩm cũng có thể bị nhiễm khuẩn trong quá trình sản xuất hay phân phối.
Nguyên nhân gây nhiễm khuẩn bệnh viện có thể phát sinh từ nhân viên y tế mang trong mình các tác nhân gây bệnh. Họ có thể có hoặc không có các biểu hiện ra bên ngoài và truyền mầm nhiễm khuẩn cho bệnh nhân.
Tuy nhiên, nguồn gốc của hầu hết ca nhiễm khuẩn trong bệnh viện là từ bệnh nhân mang trong mình các vi sinh vật gây bệnh. Các vi sinh vật này thường được thải vào môi trường với số lượng lớn, vượt quá mức nhiễm khuẩn tối thiểu, và lây bệnh cho người khác - những người này sẽ phát triển các nhiễm trùng bệnh viện.
 |
| Các nhân viên y tế thường xuyên rửa tay để tránh phát tán nguồn bệnh nhiễm khuẩn. Ảnh: KPCC. |
Vi sinh vật có thể được phát tán từ nguồn tới vật chủ mới qua tiếp xúc gián tiếp, tiếp xúc trực tiếp hay qua vật trung gian truyền bệnh như côn trùng, các loài chân đốt hay ký sinh trùng. Trong đó, tuyến đường lây lan chủ yếu của nhiễm khuẩn bệnh viện là qua tiếp xúc gián tiếp. Bệnh nhân nhiễm bệnh chạm vào một vật thể, dụng cụ hay bề mặt và để lại vi khuẩn ở đây. Sau đó, bệnh nhân khác chạm vào chúng và có thể sẽ bị nhiễm.
Hai quy tắc chính để ngăn ngừa việc lây lan nhiễm khuẩn bệnh viện tại các cơ sở y tế là cô lập nguồn gây bệnh và xóa bỏ các đường phát tán bệnh. Việc cô lập nguồn bệnh không chỉ là tách riêng những bệnh nhân nhiễm bệnh, mà còn gồm các kỹ thuật khử trùng. Mọi vật tiếp xúc với bệnh nhân nên được xem là tiềm ẩn khả năng lây bệnh, cần được loại bỏ (nếu là loại dùng một lần) hoặc làm sạch, khử trùng hoặc vô trùng (nếu là loại có thể tái sử dụng).
Nan giải nhiễm khuẩn bệnh viện ở Việt Nam
Bác sĩ Phạm Văn Tiến, Trưởng khoa Cấp cứu, Bệnh viện Quân y 103, cho biết ở Việt Nam, nhiễm khuẩn bệnh viện đang là một vấn đề nan giải. Đây được xem là nguyên nhân làm tăng tỷ lệ người bệnh tử vong, biến chứng, tăng ngày nằm điều trị, mức sử dụng kháng sinh, sự kháng thuốc của vi sinh vật, chi phí dùng thuốc và gánh nặng bệnh tật cho cả người bệnh và hệ thống y tế.
Bác sĩ Hoàng Hải Hà, khoa Nội, Bệnh viện 09, nơi điều trị cho các bệnh nhân HIV/AIDS, đặc biệt với các biến chứng lao phổi, cũng cho biết môi trường bệnh viện có rất nhiều loại vi khuẩn, type gây bệnh khác nhau. Chúng dễ dàng lây lan từ người bệnh này sang người bệnh kia thông qua quá trình cùng ở cùng một phòng, tiếp xúc hoặc thông qua nhân viên y tế.
Chẳng hạn một bệnh nhân HIV có lao nhưng khi vừa vào viện, kết quả dương tính với lao chưa có, trong thời gian đó, nếu tiếp xúc với những bệnh nhân khác hoàn toàn có thể lây bệnh.
Đối tượng nào dễ mắc nhiễm khuẩn bệnh viện
Nói về đối tượng dễ mắc nhiễm khuẩn bệnh viện, Tiến sĩ Nguyễn Việt Hùng, Trưởng Khoa Kiểm soát nhiễm khuẩn, Bệnh viện Bạch Mai, cho hay trẻ sơ sinh là đối tượng có nguy cơ nhiễm cao nhất và khi đã mắc nhiễm khuẩn, tỷ lệ tử vong sẽ cao nhất do chưa hoàn chỉnh hệ thống miễn dịch. Tỷ lệ tử vong khi mắc nhiễm khuẩn bệnh viện có thể lên tới 50%.
TS Hùng giải thích trong không khí luôn tồn tại vi khuẩn, nhưng chúng thường không gây bệnh. Vi khuẩn này sẽ thường trú trên cơ thể trẻ. Khi có can thiệp thủ thuật, sẽ mở đường cho vi khuẩn vào trong cơ thể gây ra nhiễm khuẩn. Trẻ mắc bệnh nặng cần can thiệp nhiều, nguy cơ nhiễm khuẩn cũng tăng lên.
“Vi khuẩn thường trú ngụ trên cơ thể người chủ yếu là trên da, mũi, họng, bình thường các vi khuẩn này không gây bệnh. Nhưng khi có các thủ thuật can thiệp tạo ra con đường cho vi khuẩn đi vào cơ thể con người gây ra nhiễm khuẩn. Người có hệ miễn dịch bị suy giảm, can thiệp thủ thuật, mổ… là đối tượng dễ mắc nhiễm khuẩn bệnh viện”, TS Hùng nói.
Năm 2014, dịch sởi khiến hơn 100 trẻ em nước ta tử vong, nguyên nhân lớn là kiểm soát nhiễm khuẩn kém khiến bệnh nhi bị lây chéo bệnh. Nếu không có tình trạng quá tải ở tuyến trên, cộng với việc kiểm soát nhiễm khuẩn tốt hơn, thì đã không xảy ra nỗi đau lớn cho ngành trong việc kiểm soát nhiễm khuẩn.
Theo TS Hùng, để giảm nhiễm khuẩn bệnh viện, việc đầu tiên phải giảm được lượng vi khuẩn định cư ngoài môi trường, từ đó giảm vi khuẩn định cư trên cơ thể người bệnh. Thứ hai, trong quá trình nhân viên y tế làm thủ thuật cho bệnh nhân cần đảm bảo vô khuẩn.
Bên cạnh đó, người nhà bệnh nhân cũng là một đối tượng làm lưu giữ vi khuẩn định cư ở người bệnh vì là nơi thân cận, tiếp xúc với bệnh nhân nhiều.
“Kiểm soát nhiễm khuẩn bệnh viện ở Việt Nam thực sự là một thách thức. Điều đó liên quan tới ý thức cá nhân, vai trò trách nhiệm của một người đối với mọi người. Một người không tuân thủ tốt nhiễm khuẩn thì nguy cơ nhiễm khuẩn là vẫn còn. Trường hợp có nhiễm khuẩn phun thuốc diệt khuẩn là biện pháp nên làm nhưng cũng chỉ là tạm thời. Khi có con người vào môi trường đó, nhiễm khuẩn sẽ lại có”, TS Hùng cho hay.
Một số biện pháp phòng chống nhiễm trùng khi chăm sóc bệnh nhân ở bệnh viện theo WHO:
-
Rửa tay
-
Dùng găng tay
-
Dùng khẩu trang, kính, mặt nạ
-
Mặc áo blouse
-
Dùng dụng cụ y tế đảm bảo vệ sinh
-
Kiểm soát môi trường bệnh viện
-
Giặt sạch và khử trùng các đồ từ vải


